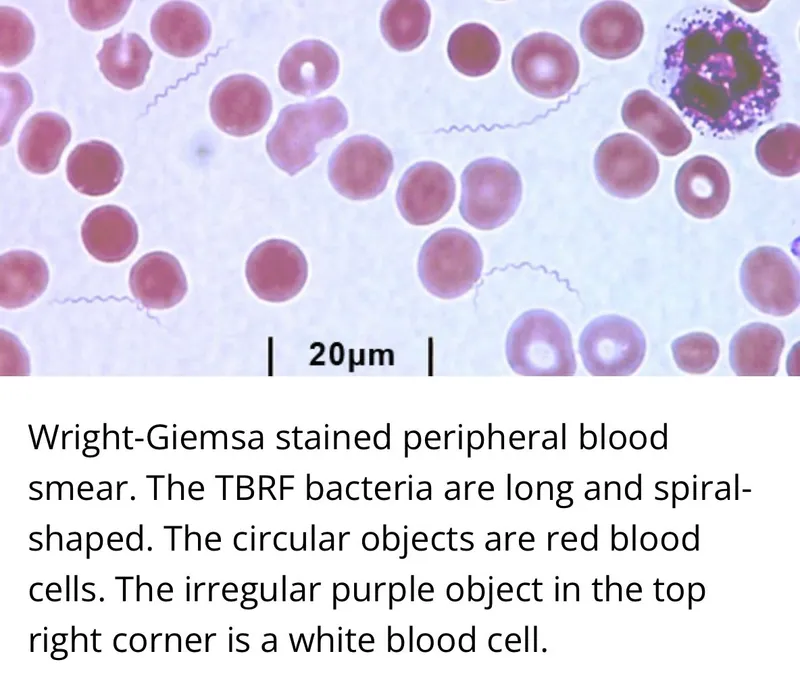
Borrelia Spirochetes in Giemsa-stained Blood Smear

Borrelia - The Great Imitator
- Organism: Spirochete (spiral-shaped bacteria); visualized via darkfield microscopy or Wright/Giemsa stains.
- Transmission: Tick-borne, primarily by Ixodes ticks.
- Lyme Disease (B. burgdorferi):
- Stage 1: Erythema migrans (bull's-eye rash).
- Stage 2: Facial nerve (Bell's) palsy, AV block.
- Stage 3: Chronic arthritis, encephalopathy.
- Relapsing Fever (B. recurrentis): Recurrent fevers due to antigenic variation.
- Treatment: Doxycycline, amoxicillin, or ceftriaxone.
⭐ A key diagnostic challenge is that the classic bull's-eye rash is absent in ~20% of Lyme disease cases.

Lyme Disease - A Tick-ing Time Bomb
- Organism: Borrelia burgdorferi (spirochete).
- Vector: Ixodes scapularis (deer tick).
- Reservoir: White-footed mouse.

Clinical Stages & Presentation
⭐ Co-infection is common with Babesia or Anaplasma phagocytophilum as they share the same Ixodes tick vector.
Diagnosis & Treatment
- Dx: Clinical (rash); Serology (ELISA, Western blot) confirms later stages.
- Tx: Doxycycline. Amoxicillin for children <8 or pregnant patients.
- 📌 Mnemonic: "BAKE a Key Lyme pie":
- Bell's Palsy
- Arthritis
- Kardiac block
- Erythema migrans
Relapsing Fever - The Comeback King
- Organism: Borrelia spp. (B. recurrentis, B. hermsii).
- Transmission:
- Louse-borne (Epidemic): B. recurrentis (human body louse).
- Tick-borne (Endemic): B. hermsii (soft Ornithodoros tick).
- Pathogenesis: Antigenic variation of surface proteins causes immune evasion and relapsing fevers.
- Presentation: Recurrent cycles of abrupt high fever, headache, and myalgia, separated by afebrile intervals.
- Diagnosis: Visible spirochetes on peripheral blood smear (Giemsa/Wright stain) during febrile periods.
- Treatment: Doxycycline. ⚠️ High risk of Jarisch-Herxheimer reaction.
⭐ The relapsing course of fever is directly due to the spirochete's ability to switch its variable major proteins (VMPs), creating new antigenic types that evade the host's antibodies.
Lab & Pharmacy - A Tale of Two Fevers
| Feature | Lyme Disease (B. burgdorferi) | Relapsing Fever (B. recurrentis) |
|---|---|---|
| Diagnosis | Serology is key (ELISA, Western blot). Spirochetes are not seen on smear. | Microscopy of peripheral blood smear (Wright or Giemsa stain) shows large spirochetes. |
| Treatment | Doxycycline is first-line. Amoxicillin or cefuroxime for children <8 or pregnant women. | Doxycycline or tetracycline. |
| Advanced Rx | IV Ceftriaxone for carditis or neurologic disease (meningitis, encephalitis). | Manage Jarisch-Herxheimer reaction. |
High‑Yield Points - ⚡ Biggest Takeaways
- Borrelia burgdorferi, a spirochete, causes Lyme disease and is transmitted by the Ixodes tick.
- Primary stage is marked by Erythema migrans, a characteristic bull's-eye rash.
- Secondary stage features include bilateral facial nerve palsy and AV nodal block.
- Tertiary stage presents with migratory monoarthritis of large joints and subtle encephalopathy.
- Diagnosis is clinical, confirmed by a two-tier serology: ELISA then Western blot.
- Treat with Doxycycline; use Ceftriaxone for late-stage or severe neurologic/cardiac manifestations.
Unlock the full lesson and continue reading
Signup to continue reading this lesson and unlimited access questions, flashcards, AI notes, and more